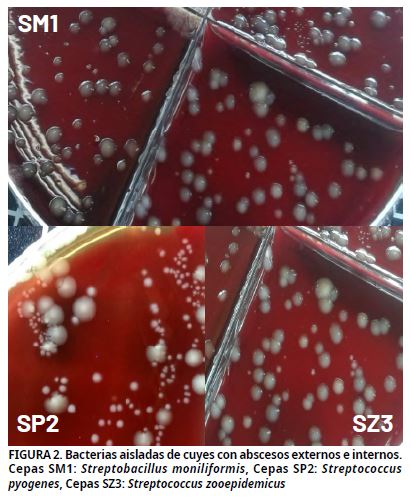
Imagen de portada
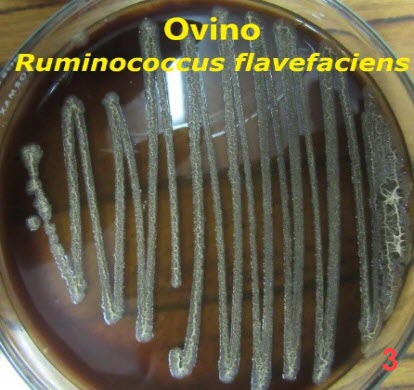
Imagen de portada

Esta Revista es indizada y/o Catalogada en:

• Science Citation Index (SCIExpanded)
• SWETS Blackwell Database
• ELSEVIER Extended Science Direct Navigator Database
• Ulrich’s Periodicals International Directory
• Veterinary Bulletin
• Index Veterinarius
• CAB Abstracts Database - UK
• Base de Datos Wildlife & Ecology Studies Worldwide
• Base de Datos de Revistas Venezolanas de Ciencia y Registro de Publicaciones Científicas y Tecnológicas Venezolanas del FONACIT - MCT
• Asociación de Editores de Revistas Biomédicas Venezolanas (ASEREME)
• Asociación Venezolana de Editores de Publicaciones de las Ciencias del Agro (AVEPAGRO)
• Base de Datos “Informe Académico” (Thomson-Gale) USA
• Base de Datos LILACS (Literatura Latinoamericana de Ciencias de la Salud)
• Base de Datos LIVECS (Literatura Venezolana en Ciencias de la Salud)
• Sociedad Iberoamericana de Información Científica (SIIC Data Bases), siicsalud. www.siicsalud.com
• Citefactor Journals Citefactor.org. Director Indexing of International Research Journals
• Institute for Scientific Information (ISI): Research Alert® y Focus on: Veterinary Science & MedicineTM
Revista Científica. Facultad de Ciencias Veterinarias. Universidad del Zulia. Núcleo Agropecuario Ciudad Universitaria. Apartad. 15252, Maracaibo 4005-A Estado Zulia-Venezuela.
p-ISSN: 0798-2259 l- ISSN: 2477-944X e-ISSN: 2521-9715
Correo: revistafcv@gmail.com
Esta obra está bajo la licencia:
Creative Commons Reconocimiento-NoComercial-CompartirIgual 4.0 Internacional (CC BY-NC-SA 4.0)

© 2021 Sistema de Servicios Bibliotecarios y de Información. Universidad del Zulia. Maracaibo, Venezuela
https://jsdlp.ogeesinstitute.edu.ng/
https://businessintelligenceinfo.com/